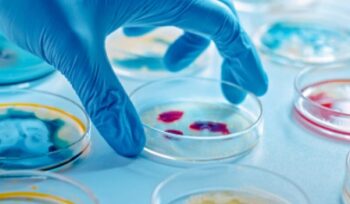

-
Distribuyen la vacuna contra el dengue a 11 provincias del país
22 de enero de 2026 -
La Ciudad busca fortalecer la Red de Odontología
22 de enero de 2026 -
Cómo ayudar a los niños y adolescentes para que logren un buen dormir
21 de enero de 2026 -
Tres terapias genéticas que pueden revolucionar el futuro de la biotecnología en 2026
21 de enero de 2026 -
El Garrahan fue destacado en Uruguay por una investigación sobre cáncer de tiroides pediátrico
21 de enero de 2026 -
H3N2: confirmaron la primera muerte en la Argentina
21 de enero de 2026 -
Fundación Favaloro incorpora un nuevo resonador magnético
21 de enero de 2026 -
Hospital Italiano: 500 trasplantes de corazón
21 de enero de 2026 -
La Ciudad inició la vacunación contra el Virus Sincicial Respiratorio
20 de enero de 2026 -
Proponen una nueva estrategia para eliminar bacterias multirresistentes
20 de enero de 2026 -
Uruguay: campaña de vacunación en el embarazo
20 de enero de 2026 -
Paraguay: exponen avances y desafíos para el 2026
20 de enero de 2026